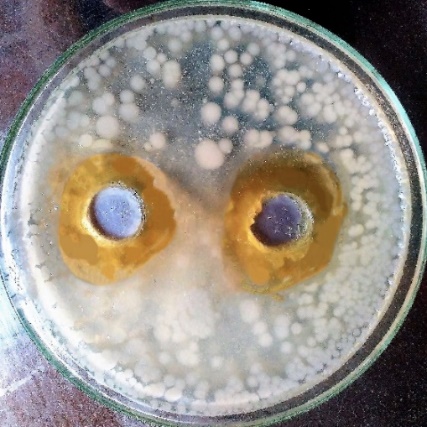

Int J Curr Pharm Res, Vol 9, Issue 5, 97-99Original Article
VIRTUAL SCREENING OF STILBENE ANALOGUE AND INSILICO, IN VITRO ANTIPROTOZOAL EVALUATION OF LEAD MOLECULES
G. LALASA*, S. VIJAYARAJ, K. THAMIZHVANAN, K. CHAITHANYAVEENA
Department of Pharmaceutical Analysis, Sree Vidyanikethan College of Pharmacy, Sri Sainath Nagar, Chandragiri (Mandal), Tirupati, Chittoor (Dist), A. P.
Email: lalasa.sudha@gmail.com
Received: 24 May 2017, Revised and Accepted: 22 Jul 2017
ABSTRACT
Objective: The objective of present study is the virtual screening of stilbene analogues followed by the in silico and in vitro evaluation for its anti protozoal activity.
Methods: The method of virtual screening selected is the structure-based virtual screening using ChEMBL database. The in silico analysis was performed using auto dock tools 4.2. The docking was performed using 1T5F (Arginase I-OH complex) as the binding proteins which are drawn from the protein data bank.
Results: The stilbene analogues from virtual screening are allowed to dock with the proteins the binding energies and docking positions were determined using auto dock tools 4.2. The in vitro evaluation of anti protozoal activity was performed.
Conclusion: The stilbene analogues are capable of producing the antiprotozoal activity.
Keywords: Stilbene analogues, Virtual screening, Protein data bank, Docking
© 2017 The Authors. Published Published Innovare Academic Sciences Pvt Ltd. This is an open access article under the CC BY license (http://creativecommons.org/licenses/by/4.0/)
DOI: http://dx.doi.org/10.22159/ijcpr.2017v9i5.22148
INTRODUCTION
Stilbene analogues are generally used in the treatment of cancer. Combretastatin chemically known as 5-[(2s)-2-hydroxy-2-(3,4,5-tri methoxyphenyl)ethyl]-2-methoxyphenolfig. 1. Combretastatin shows their activity by binding to tubulin and also induce vascular shutdown and necrosis in tumours [1]. Clinical trials have revealed its positive effects, either as a single agent or in combination with chemotherapy, in patients with ovarian, lung or anaplastic thyroid cancer.
Tubulin represents a potent target in cancer chemotherapy, given its role in cell division. Combretastatin is a naturally occurring well-known tubulin polymerization inhibitor. Biochemical analyses revealed that CA4P rapidly diminished [2]. The articles have been reported that the repositioning of anti-cancer may also exhibit the anti protozoal activity by zone of inhibition method. Current research work is devoted to performing the virtual screening, in-silico analysis and in-vitro evaluation of stilbene analogues for its anti protozoal activity [3-5].

Fig. 1: Structure of combretastatin
MATERIALS AND METHODS
Softwares and applications used
ChEMBL is selected as the database to perform the virtual screening. Chembl or chembldb is a manually curated chemical database of bioactive molecules with drug-like properties. The chembio3ddraw is used to generate the pdb forms of the ligands which are visually screened ChEMBL, Chemdraw is a molecule editor used in the generation of molecules for in silico analysis. Autodock 4.2a software which performs the automated docking of flexible ligands to flexible receptors, introduced by Garret m. Morris et al., popularly known as auto dock with version 4.2 were used in the present study to study the molecular docking [6].
Laboratory equipment’s used
Electronic weighing balance (Shimadzu), autoclave, BOD incubator (biotechincs), and laminar air flow chamber. Combretastatin and quercetin were purchased from Sigma Aldrich, Dimethyl sulfoxide is used as a solvent.
Methodology
Virtual screening
Chembldata base was selected as screening software for the present study. In this study structure based mode of virtual screening was performed. Basic moiety of stilbene analogues was drawn in the screening software by using JSME drawer and the similarity was set to ≥ 70%. After completion of screening of stilbene analogues, 20 hit molecules were observed. Among them, combretastatin was selected.
In silico analysis
The auto dock 4.2 program was used to locate the appropriate binding orientations and conformations of combretastatin on arginase receptor (PDB Id: 1T5F). Autodockis an extensively used automated procedure for predicting the interaction of small molecules, such as peptides, enzyme inhibitors, and drugs, to macromolecules, such as proteins, enzymes, antibodies, DNA and RNA. The structure of the arginase receptor (PDB Id: 1T5F) were obtained from protein data bank.
Molecular structures of combretastatin were built using the chem-bio draw Ultra 11.0 version. Geometry optimisations of all derivatives were carried out using the Tripos force field with a distance-dependent dielectric and the Powell conjugate gradient algorithm. Gasteiger-huckel charges were used.
Docking procedure
All the water molecules, TMC 125 (ligand) and magnesium ions were removed from the original protein data bank file. Polar hydrogen atoms were added. Gasteiger charges, atomic solvation parameters and fragmental volumes were assigned to the protein. All the torisions in combretastatin were treated as flexible by allowing them to rotate freely. Autogrid 4.0+was used to calculate the grid maps with 40 x 40 x 40 points, a grid-point spacing of 0.375 å and the maps were centred on the ligand. The Lamarckian genetic algorithm (lga) in auto dock 4.0 was used to explore the energy landscape [7].
The hybrid search technique consists of a global optimizer modified from a genetic algorithm with 2-point crossover, random mutation, and a local optimizer with a solid and wets algorithm. A docking box of 40 x 40 x 40 points with a grid spacing of 0.375 å was used in the calculations. Random conditions were used in the settings of seed, initial quaternion, coordinates, and torsions. A 0.2 å step was used for translation and a 25-degree was used for quaternion and torsion [8]. The maximum number of energy evaluation was 250000, and the maximum number of generations was 27000.
The rate of gene mutation was 0.02, and the rate of crossover was 0.8. The number of cycles was set to 10. So a total of 10 docking configurations were determined in each docking calculation. A “preferable” docking configuration was chosen based on the lowest empirical binding free energy and the most frequent cluster [9, 10].
In vitro antiprotozoal activity
In this study, rhizopodial-culture was selected as protozoal strain. The microorganism was allowed to grow overnight at 37 °C in 2% nutrient broth at pH 7.
Preparation of inoculums
The inoculum was prepared by inoculating a loop of each protozoal strain from 24 h old culture into a sterile nutrient broth aseptically in the laminar air flow unit. The culture growth was allowed for 24 h in an incubator at 37 °C.
Determination of antiprotozoal activity
By using agar well diffusion method determination of anti protozoal activity was performed. The agar plates were prepared by pouring 20 ml of sterile molten Muller-Hinton (MH) agar. The protozoal culture was prepared by adding the seed culture in the autoclaved agar medium followed by pouring into the Petri plates. The solid agar medium was gently punctured with the aid of 8 mm sterile cork borer to make a proper well. 1 ml of Combretastatin was added in the pre-labelled wells together with standard antiprotozoal drug Quercetin. The standard Quercetin drug is used in the concentration of 1000µg/ml. It was taken care that the sample should be placed at the level of the cavity. The diffusion of the sample was allowed for 1hr at room temperature on a sterile bench.
Then the Petri plates were incubated for 48 h at 37 °C. After 48 h the plates were observed for the presence of inhibition of protozoal growth and that was indicated by an aclear zone of inhibition of protozoal growth around wells. The size of the inhibitory zone was measured in millimetres.
RESULTS AND DISCUSSION
Virtual screening of stilbene analogues was performed using ChEMBL. The structure-based virtual screening was done by using 70% similarity. After screening, 20 hits were observed. Among 20hits combretastatin was selected for the present study based on the commercial availability. In silico studies were performed following the virtual screening.
In silico analysis of stilbene analogues ie., combretastatin and quercetin which was selected as standard were performed and docking positions and binding energies were determined. The docking studies of target compounds were performed using the binding pocket of Arginase I-OH complex (PDB Id: 1F5F).
In silico analysis of quercetin with arginase receptor (1t5f)

Fig. 2: Docking position of quercetin with arginase receptor (PDB Code: 1T5F)
The docking results disclosed that targeted molecules exhibited considerable and diverse binding affinities of quercetin towards 1T5F (14.28 to-11.41) along with the formation of numerous hydrogen bonds, π–σ interactions with ARG 255, VAL 249, VAL 239, ASP 237, SER 253 and GLU 256 amino acid residues of 1T5F (Arginase I-OH complex). The bond length of the interactions was estimated and illustrated in table 1.

Fig. 3: Docking position of combretastatin on arginase receptor ((PDB Code: 1T5F)
The docking results disclosed that targeted molecules exhibited considerable and diverse binding affinities of combretastatin towards 1T5F (-12.27 to 10.11) along with the formation of numerous hydrogen bonds and π–σ interactions with ASP 237, ASP 255 and SER 253 amino acid residues of 1T5F (Arginase I-OH complex). The bond length of the interactions was estimated.
In vitro antiprotozoal studies
Fig. 4: Zone of inhibition of quercetin against rhizopoda.
Table 1: Table representing various bond lengths, bond angles and amino acid residues
| S. No. | Drug name | 1T5F | Amino acid residues | Binding | |
| Interactions observed | Bond length(A °) | Energies (kcal/mol) | |||
| 1. | Quercetin | π–ϭ π–ϭ π–ϭ Hydrogen bonds |
6.423 5.262 6.423 6.330 3.066 2.637 2.736 |
ARG 255 VAL 249 VAL 239 ASP 237 SER 253 GLU 256 GLU 256 |
-14.28 |
| 2. | Combretastatin | π–ϭ Hydrogen bond Hydrogen bond |
6.826 5.452 7.454 |
ARG255 ASP 237 SER 253 |
-12.27 |
By observing the docking positions and binding energy the stilbene analogues ie., combretastatin shows a good affinity towards the antiprotozoal protein 1T5F (Arginase I-OH complex).
In vitro antiprotozoal activity for quercetin and combretastatin were performed. The drug was diffused into nutrient agar medium which contains the rhizopoda (protozoa). The zone of inhibition was observed after 48 h of incubation at 37 °C and it was found to be 6 mm

Fig. 5: Zone of inhibition of combretastatin against Rhizopoda
Invitro anti protozoal activity for quercetin and combretastatin were performed. The drug was diffused into nutrient agar medium which contains the rhizopoda (protozoa). The zone of inhibition was observed after 48 h of incubation at 37 °C and it was found to be 3 mm respectively.
CONCLUSION
Virtual screening of selected pharmacophore was successfully performed, the stilbene analogues combretastatin was chosen for the study. Insilico docking studies of stilbene analogue, Combretastatin was successfully performed. Insilico docking studies shown that the stilbene analogues have a least binding affinity towards 1T5f (Arginase I-OH complex). A significant correlation was observed between the silicon and in-vitro studies of selected analogues. Combretastatin showed the antiprotozoal activity. Further establishment of combretastatin as antiprotozoal can be done by in-vivo evaluation.
ACKNOWLEDGEMENT
Authors are thankful to Dr. M. Mohanbabu, Chairman, Sree Vidyanikethan Educational institutions, Tirupati, India for continuous motivation, support, and for providing the necessary infrastructure to carry out this work.
CONFLICT OF INTERESTS
The authors declare no conflicts of interest
REFERENCES
Renata Mikstacka. Tubulin-interactive stilbene derivatives as anticancer agents. Cell Mol Biol Lett 2013;18:368-97.
www.drugbank.ca/drugs/DB05143 [Last accessed on 10 Apr 2017].
Sean Ekins. In silico repositioning of approved drugs for rare and neglected diseases. Drug Discovery today 2011;16:7-8.
Wodak SJ, Janin J. Computer analysis of protein-protein interaction. J Mol Biol 1978;124:323–42.
Walters WP, Murcko MA. Library filtering systems and prediction of drug-like properties. In virtual screening for bioactive molecules. Wiley-VCH 2000:10:15–32.
Kuntz ID, Blany JM, Oatley SJ, Langridge R, Ferrin TE. A geometric approach to macromolecule-ligand interactions. J Mol Biol 1982;161:269–88.
Mugge I, Enyedy I. Virtual screening. In: Burger’s Medicinal chemistry and Drug discovery. 6th Vol. 1. Verginia: Wiley Interscience; 2003. p. 243–79.
Shoichet BK. Virtual screening of chemical libraries. Nature 2004;432:862–5.
Tondi D, Slomczynska U, Costi MP, Watterson DM, Ghelli S, Shoichet BK. Structure based discovery and in-parrallel optimization of novel competitive inhibitors of thymidylate synthase. Chem Biol 1999;6:319–31.
Walters WP, Murcko MA. Library filtering systems and prediction of drug-like properties. In Virtual Screening for Bioactive Molecules. Wiley-VCH 2000:10:15–32.
How to cite this article
Virtual screening of stilbene analogue and in silico, in vitro antiprotozoal evaluation of lead molecules. Int J Curr Pharm Res 2017;9(5):97-99.